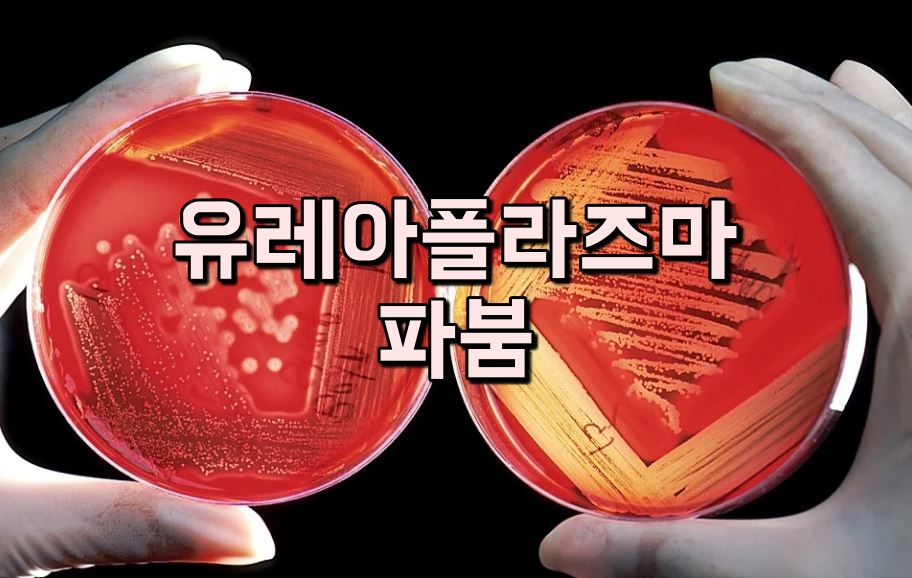

산부인과에서 가장 많이 하는 검사 중 하나가 바로 STD검사합니다. 성 매개성 감염질환 검사인데 성관계로 인해 감염될 수 있는 세균이나 바이러스에 대한 검사를 말합니다. 흔히 성병으로 알려져 있는 유레아플라즈마는 성매개감염질환을 검사하는 STD 12종 검사의 하나에 속합니다.
유레아플라즈마는 두가지 종류로 나누어지는데 파붐의 경우 성병으로 분류되지 않습니다. 질병을 일으키는 능력이 약하기 때문에 병원균이 아닌 공생균으로 분류되기도 하는데 정상적인 상태에서도 여성의 질, 요도 등에서 발견되지 때문으로 유레아플라즈마 파붐(Ureaplasma pavum)으로 흔하게 발견되는 세균 중 하나입니다.
유레아플라즈마 파붐은 성접촉으로 전파되기도 하지만, 성관계가 전혀 없었던 여성의 질 내부에서도 발견되며 항셍제로 치료하지 않아도 몸에 별 이상을 일으키지 않는 경우가 많습니다. 그렇기 때문에 공생균 혹은 상재균으로 취급되고 있습니다.
유레아플라즈마 파붐
유레아플라즈마 파붐으로 인해 나타날 수 있는 증상으로 질 내부에서 염증을 일으킨다면 황색이나 회백색의 질 분비물, 냄새, 가려움 등으로 세균성 질염 증상이 나타납니다. 또한 요도염의 원인이 될 수 있는데 남성의 요도 끝에 잠복해 있던 균에 의해 관계 시에 요도 끝이 닿아서 감염되기도 하며, 관계 시에 질 내부에 있던 균이 마찰에 의해 밖으로 나온 후 요도로 밀려 들어가 감염되어 요도염을 일으킬 수도 있습니다.
유레아플라즈마 파붐 성별에 따른 증상
유레아플라즈마 파붐 여성의 경우 하복부의 불편한 느낌, 소변을 자주 보게 되는 빈뇨, 밤에 소변이 자주 마려운 야간뇨, 혈뇨 등과 함게 분비물 증가가 동반되는데 처음에는 균의 수가 많지 않아 별다른 이상이 없는 무증상인 경우도 많습니다. 균이 숫자가 늘어남에 따라 냉에서 악취가 나고 노란색, 녹색 분비물이 나오기도 합니다.
유레아플라즈마 파붐 남자의 경우 요도염이 많이 나타나며 가려움, 소별볼 때 통증, 하복부통증 및 점액의 농성 분비물 등이 나올 수 있습니다.
유레아플라즈마 파붐의 경우 남성보다는 여성의 치료가 더 까다로우며 남성의 경우 소변을 보며 요도를 통해 균이 씻겨나가는 경우도 많지만 여성의 경우 균이 질 내에 남기 쉽고 완전히 균이 사라지지 않으며 합병증으로 진행될 수 있기 때문에 제대로 치료받는 것이 중요합니다. 제대로 치료받지 않으면 남녀 모두에게서 불임합병증이 발생할 수 있습니다. 남성은 부고환염, 여성은 난관염, 만성골반통, 골반염 등의 합병증이 나타날 수 있는데 산모가 감염된 경우 조산의 가능성을 높인다고 합니다.
유레아플라즈마 파붐 치료방법
하지만, 파붐 증상이 없더라도 유레아플라즈마 파붐균이 검출되었다면 증상이 없더라도 항생제를 처방하는 경우가 있지만 무증상에서는 항생제를 복용할 필요는 없지만 균이 검출된 상태에서 질염이나 요도염 등의 증상이 나타난다면 반드시 항생제를 복용하여 치료해야 합니다.
항생제치료를 시작하면 독시사이클린, 아지스로마이신 등의 계열 항생제를 복용하게 되는데 증상이 사라지더라도 항생제는 반드시 처방받는 날짜까지 꾸준히 복용해야 하며, 치료 시작 후 2~3주 이내에 한번 더 검사를 받아서 균이 완전 사라졌는지를 확인해야 합니다. 감염이 심할수록 골반염, 부고환염 등 합병증 발생 위험성이 있으니 치료는 필수적입니다.
무엇보다 의미없는 항생제 복용보다는 질 내 유산균이 건강하게 유지될 수 있도록 생활습관을 개선하고 질 내 유산균을 복용하는 것이 도움이 되니까 이전 포스팅을 참고하세요.
여성질유산균 트루락이브 아내선물
유산균이 다 같은 유산균이 아닌 듯 여성의 질과 장건강을 한번에 챙기는 여성질유산균이 따로 있네요. 이거저것 찾아보던 중 발견한 여성유산균 트루락이브 아내선물로 구입 한달분이 4만원대
shoppingguy.tistory.com
지금까지 몰랐던 질유산균! 알고부터는 꾸준히 구입해서 아내가 복용하고 있는데 좋네요.
'소소한정보' 카테고리의 다른 글
| 넷플릭스 VS 디즈니플러스 뭐가 좋을까 (0) | 2021.11.02 |
|---|---|
| 보령해저터널 개통 및 통행료 정보 (0) | 2021.11.01 |
| 전문가에게 듣는 오래된 시계관리방법 (0) | 2021.10.28 |
| 선착순배포 소비할인권 이용 신청방법 (0) | 2021.10.27 |
| 2022 스타벅스 다이어리 e프리퀀시 적립시 주의사항 (0) | 2021.10.26 |


